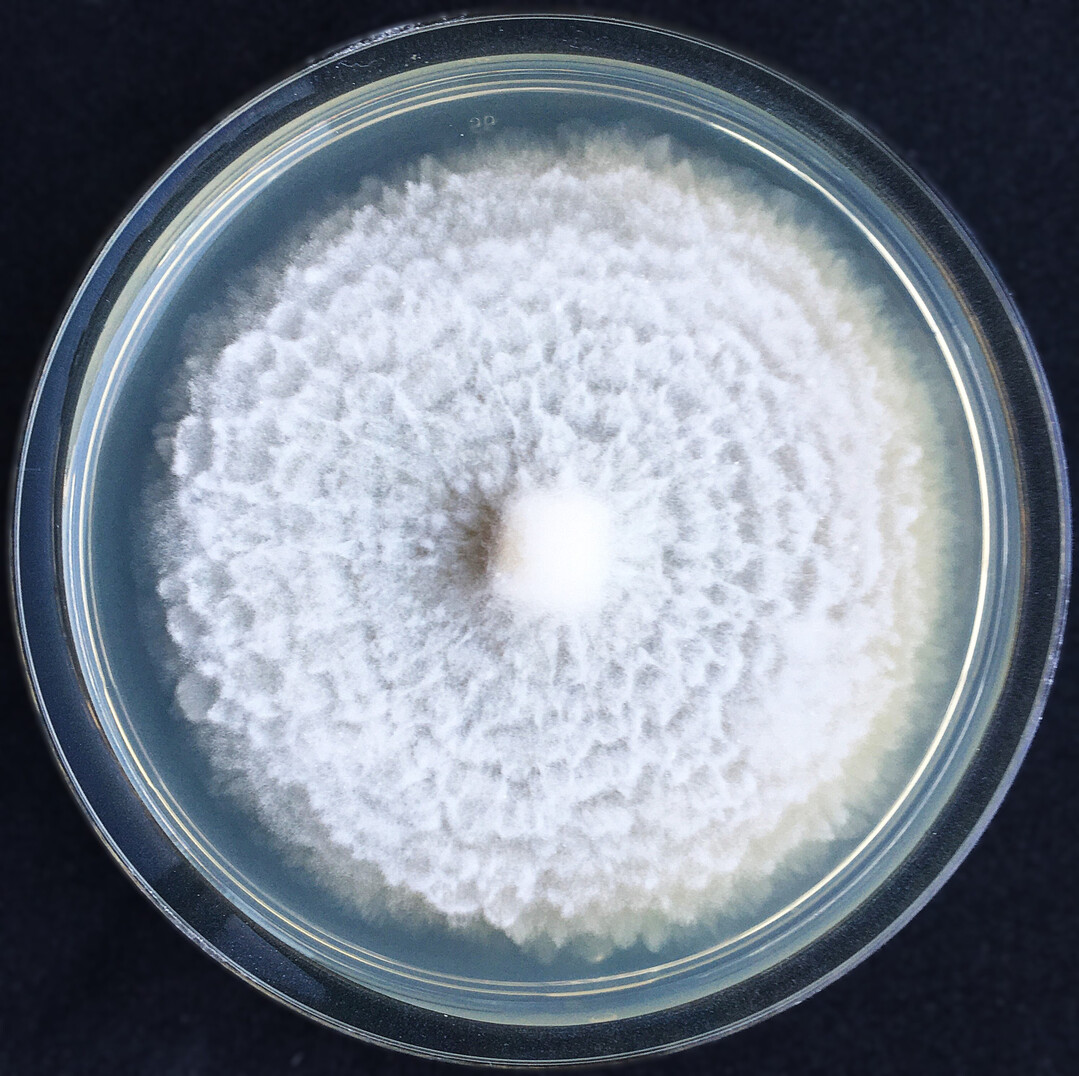
Der Pilz 
<i>Mortierella alpina</i>
 k�nnte in der Landwirtschaft als Mittel gegen Nematoden funktionieren. Hierf�r bedarf es aber noch einiges an Forschung.

Ein Pilz als Pflanzenretter?
Der Bodenpilz Mortierella alpina hat das Potenzial, die Landwirtschaft grüner und nachhaltiger zu gestalten: Der Pilz produziert bioaktive Moleküle namens Malpinine, die Pflanzen vor zerstörerischen Würmern schützen könnten. Ein Forschungsteam aus Jena konnte nun erstmals deren Wirkweise nachvollziehen und näher beschreiben.
Die Geschichte beginnt unter unseren Füßen: Böden sind nicht nur ein komplexer Lebensraum, sondern auch ein Schlachtfeld, auf dem winzige Fadenwürmer, die Nematoden, gegen Pilze und Pflanzenwurzeln antreten. Darunter leidet vor allem die Landwirtschaft. Aus Sorge vor Ernteverlusten werden die Würmer konventionell mit chemischen Pflanzenschutzmitteln bekämpft. Diese stehen jedoch zunehmend in der Kritik, da sie möglicherweise Böden und Wasser schädigen. Mit Blick auf die Zukunft müssen für eine nachhaltige Landwirtschaft Alternativen gefunden werden.
Im Gegensatz zu uns Menschen kennt der Bodenpilz Mortierella alpina schon lange einen natürlichen Trick gegen Nematoden: Er produziert spezielle Moleküle, die seinen Fressfeinden das Leben schwer machen. Diese oberflächenaktiven Naturstoffe heißen Malpinine und fungieren als natürliche Detergenzien. „Frühere Studien hatten schon gezeigt, dass der Pilz Nematoden bekämpfen kann, aber der molekulare Wirkmechanismus dahinter war noch unbekannt. Wir wollten diesen aufklären“, sagt Erstautorin Dr. Hannah Büttner vom Leibniz-Institut für Naturstoff-Forschung und Infektionsbiologie – Hans-Knöll-Institut (Leibniz-HKI).
Mortierella alpina, der vor allem in Böden gemäßigter und kühler Regionen vorkommt, könnte ein Schlüssel zu einer nachhaltigen Landwirtschaft sein. „Wenn wir herausfinden, wie genau Mortierella gegen Nematoden wirkt, könnten wir diesen Pilz vielleicht gezielt als Mittel zur biologischen Kontrolle gegen Pflanzenpathogene einsetzen“, so Büttner, die soeben erfolgreich ihre Doktorarbeit abgeschlossen hat.
Malpinine stören die Verdauung der Würmer
Die Wissenschaftler haben für die Studie die Wirkung der Malpinine an Modell-Nematoden untersucht. Um die Naturstoffe live in den Nematoden verfolgen zu können, verwendeten sie bildgebende Verfahren wie Fluoreszenzmikroskopie und Raman-Spektroskopie in Kooperation mit Constanze Schultz vom benachbarten Leibniz-Institut für Photonische Technologien. „Wir konnten beobachten, wie sich die Malpinine gezielt im Verdauungstrakt der Würmer ansammeln“, erläutert Büttner. „Die Nematoden starben aber nicht sofort, sondern stellten die Nahrungsaufnahme ein. Dies führte schließlich zu einer zwar langsamen, aber effektiven Kontrolle der Würmer.“
Besonders bemerkenswert ist die chemische Struktur der Malpinine, die ihre wurmtötende Wirkung erst ermöglicht. Entscheidend dabei ist vor allem ein spezieller Baustein: die ungewöhnliche Aminosäure Dehydrobutyrin.
„Dehydrobutyrin besitzt eine reaktive Doppelbindung und könnte deshalb Reaktionen mit Molekülen eingehen, die für die Funktion des Nematodendarms essenziell sind“, erklärt Co-Autor Johannes Raßbach vom Institut für Pharmazie der Friedrich-Schiller-Universität Jena. Diese Reaktionen könnten beispielsweise wichtige enzymatische Prozesse im Verdauungstrakt der Schädlinge stören oder die Membranstruktur beeinträchtigen. Versuche zeigten, dass Varianten der Malpinine, bei denen die Aminosäure durch eine weniger reaktive Struktur ersetzt wurde, ihre Wirkung komplett verloren. „Dies weist darauf hin, dass genau diese Struktur für die biologische Aktivität unerlässlich ist. Ohne sie ist die Verbindung wirkungslos“, so Raßbach.
Die Forschenden vermuten, dass ihr einzigartiger Aufbau es den Malpininen ermöglicht, sowohl in den Körper der Nematoden einzudringen als auch dort gezielt zu wirken.
Ökologische Alternative zu chemischen Pflanzenschutzmitteln?
Die Erkenntnisse aus der Studie könnten zu einer nachhaltigen Landwirtschaft beitragen. Chemische Pflanzenschutzmittel bergen immer gewisse Umwelt- und Gesundheitsrisiken. Natürliche Alternativen wie die Malpinine könnten dagegen umweltfreundliche Lösungen sein, zumal Mortierella-Pilze oft mit gesunden Böden assoziiert werden. „In der Biotechnologie wird Mortierella schon lange genutzt, zum Beispiel für die Herstellung von Babynahrung. Um ihn auch sicher und effektiv in der Landwirtschaft einsetzen zu können, müssen wir den Pilz aber erst noch weiter erforschen“, betont Raßbach.
Die Studie wurde im Rahmen des Sonderforschungsbereiches „ChemBioSys“ und des Exzellenzclusters „Balance of the Microverse“ der Friedrich-Schiller-Universität Jena durchgeführt. Das interdisziplinäre Forschungsprojekt untersucht, wie mikrobielle Gemeinschaften in verschiedenen Lebensräumen miteinander und mit ihrer Umgebung interagieren. Das Cluster möchte grundlegende Prinzipien der mikrobiellen Balance verstehen, um diese in der Medizin, Landwirtschaft, Umweltwissenschaft und Biotechnologie anzuwenden und nachhaltige Lösungen für globale Herausforderungen wie Klimawandel, Lebensmittelknappheit und Gesundheitsprobleme zu entwickeln. Gefördert wurden die Arbeiten unter anderem mit Mitteln der Deutschen Forschungsgemeinschaft, des Landes Thüringen und der EU.